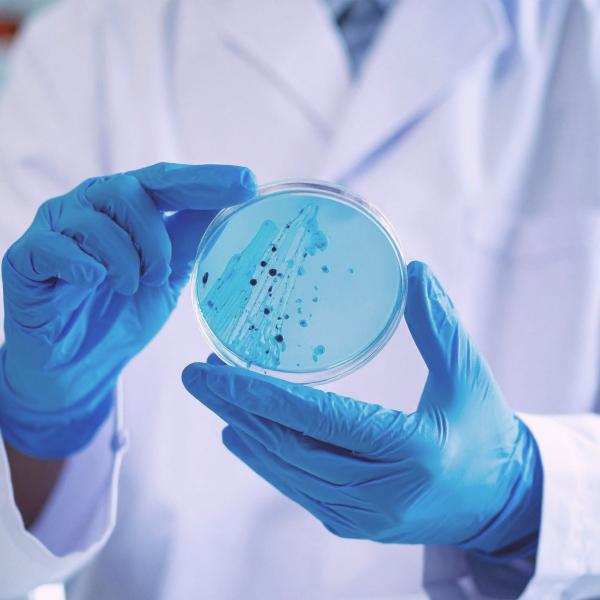

Parodontologia e cura della piorrea
La parodontologia è quella specialità dell’odontoiatria che si occupa di studiare il parodonto e le patologie ad esso connesse. I primi interventi, per provare a salvare i denti con la chirurgia parodontale, risalgono al lontano 1884 con il Dr. Robicsek ovviamente le tecniche si sono evolute moltissimo specie negli ultimi anni dopo l’avvento della microchirurgia parodontale attraverso ingrandimenti e l’utilizzo di fili di sutura dedicati 6-0 e 7-0 quasi invisibili a occhio nudo.
Anche la terapia parodontale non chirurgica ha fatto passi da gigante grazie alle microcourette e l’avvento del laser.
Clinica all’avanguardia per il trattamento della parodontite
Grazie all’utilizzo di un’innovativa metodica digitale, il paziente può visualizzare in 3D la sua reale perdita ossea conseguente alla parodontite ed i nostri medici possono pianificare un trattamento terapeutico più mirato.